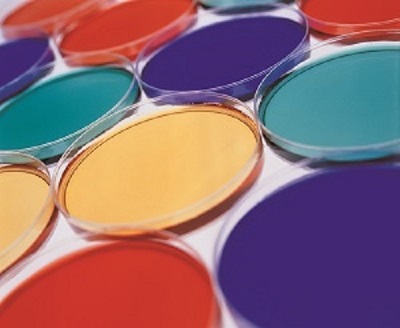
Pigment

Company Information
Ask for more detail from the seller
Contact Supplierwe offers Pigment.
Colour properties:
relative tinting strength:
reduction:
full shade:
light
hue:
chroma:
transparency:
95 - 105 %
dl = ± 0.5 cie lab units
dh = ± 0.5 cie lab units
dc = ± 0.8 cie lab units
de = 0.0 – 1.0 cie lab units
dl = ± 0.5 cie lab units
dh = ± 0.5 cie lab units
dc = ± 0.8 cie lab units
de = 0.0 – 1.0 cie lab units
close to standard, ± 2 visual assessment units
3 ph-value: 6.0 – 9.0
4 specific conductivity: 0.5 mscm
5 volatile matter (105℃): 2.0 %
6 sieve residue (din 53195): 0.2%
water soluble
(iso 787)
1.0%
enclosure
notes to the product specification.
this specification will not be signed. It has been automatically printed.

